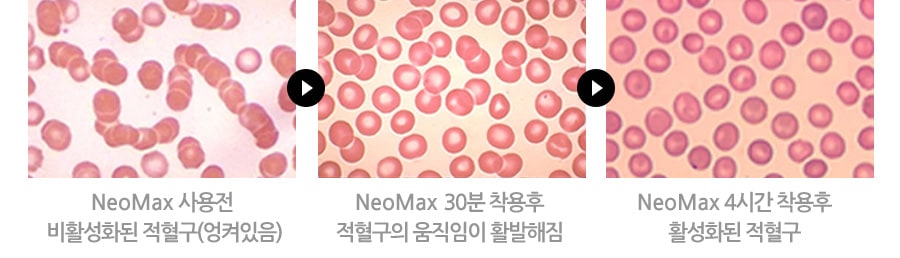
NEOMAX-Red-blood-cells

Home > 제품소개 > 가죽 자석 팔찌
가죽 자석 팔찌


12개의 강력한 자석이
손목 경혈부분 자극
3,000가우스의 강력한 자력을 가진 12개의 슈퍼자석이
손목 경혈부분을 자극할 수있도록 설계되어 혈액순환을 개선하고
근육통 완화의 효과를 좌우합니다.


자기 요법의 효과 극대화
모든 자석의 N극이 피부를 향하도록 제작되어
자기요법의 효과가 극대화됩니다.

적혈구 사진 (NeoMax 착용 전후 사진)

사이즈 선택 이렇게 하세요
(S/M/L)
- 손목에 압박감 없이 0.5cm의 여유를 두고 가볍게
손목에 위치한 경혈 부위를 터치하는 정도의 사이즈를 선택하시면 좋습니다.
- 패션 아이템으로 착용하시면서 99,99%의 게르마늄과
강력한 자력의 기능을 동시에 체험해 보세요.
- 끊어진 경우 A/S가 불가능하오니 착용시 과도하게 늘리시지 마십시오.

자석의 작용 원리


